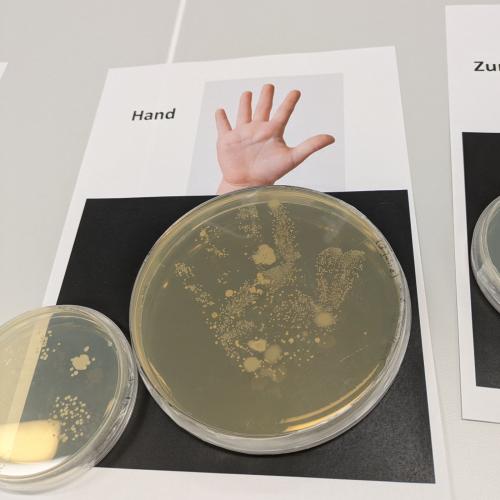
bei den Open Lab Days

Open Lab Days: Molekulare Medizin
Am 17. 2. konnten interessierte Schülerinnen und Schüler der 7R an den Open Lab Days der Medizinischen Universität Innsbruck teilnehmen. Dabei bekamen sie Einblicke in das Bachelor Studium der Molekularen Medizin. Interessante Vorträge und Einheiten im Labor wechselten sich ab. Die Themen reichten von der Zelle über das Gehirn bis zum Nutzen der Fruchtfliege für die Forschung und die Bedeutung von Schimmelpilzen.
Im Labor konnten die Schüler:innen Gewebeschnitte einfärben und das richtige Desinfizieren der Hände erproben. Im Fluoreszenzmikroskop konnten die unterschiedlichen Zellorganellen betrachtet und identifiziert werden.
Es war ein interessanter und abwechslungsreicher Vormittag!
Prof. Ulrike Demel